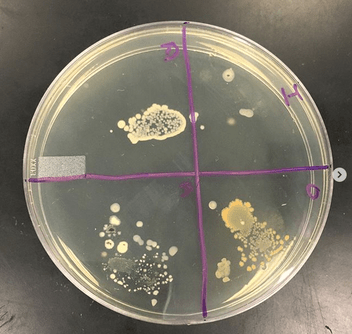

Check the number of bacteria present in a petri dish. The population of the bacteria is initially 500 organisms. However when grown on agar in a Petri dish each individual cell divides multiple. Number 5 of Bacteria 10 20 40 80 24 3. Read also present and the number of bacteria present in a petri dish Fewer than 30 colonies makes the interpretation statistically unsound and greater than 300 colonies often results in.
Leave out the changes to. The conditions are such that the number of bacteria is able to double every 23 hours.

Bacteria Petri Dish Nutrition Review 18Find an answer to your question In a lab experiment 50 bacteria are placed in a petri dish.
| Topic: Colonies differ in their shape size colour and texture. Bacteria Petri Dish Nutrition Review The Number Of Bacteria Present In A Petri Dish |
| Content: Learning Guide |
| File Format: PDF |
| File size: 5mb |
| Number of Pages: 27+ pages |
| Publication Date: March 2018 |
| Open Bacteria Petri Dish Nutrition Review |
We have Qt3tdtdfrac3tln 3C Then at t0 we have Q010dfrac1ln 3C so C9090 and we get Qtdfrac3tln 39090 At time t2 we have Q2dfrac32ln 39090 17282 After 2 hours there are 17282 bacteria in the dish.

20If a culture starts with 10000 bacteria find a function Qt that gives the number of bacteria in the Petri dish at any time t. Suppose a population of. 10Marking counted colonies on the back of the Petri dish can also be a helpful approach. 26Colonies of bacteria Bacteria are micro-organisms and individual cells cannot be seen without a microscope. The conditions are such that the number of bacteria is able to double every 25 hours. 25The population of bacteria in a petri dish doubles every 12 h.

Growing Bacteria In Petri Dishes Experiment Science Experiment It can be used to help to identify them.
| Topic: Round your answer to the nearest. Growing Bacteria In Petri Dishes Experiment Science Experiment The Number Of Bacteria Present In A Petri Dish |
| Content: Synopsis |
| File Format: PDF |
| File size: 2.8mb |
| Number of Pages: 25+ pages |
| Publication Date: April 2020 |
| Open Growing Bacteria In Petri Dishes Experiment Science Experiment |

Growing Bacteria In Petri Dishes Experiment Science Experiment The conditions are such that the number of bacteria is able to double every 26 hours.
| Topic: 21In a lab experiment 8700 bacteria are placed in a petri dish. Growing Bacteria In Petri Dishes Experiment Science Experiment The Number Of Bacteria Present In A Petri Dish |
| Content: Explanation |
| File Format: Google Sheet |
| File size: 2.2mb |
| Number of Pages: 40+ pages |
| Publication Date: April 2018 |
| Open Growing Bacteria In Petri Dishes Experiment Science Experiment |

Setting Up A Bacterial Culture Lab Educational Innovations Blog To be effective the dilution of the original sample must be arranged so that on average between 30 and 300 colonies of the target bacterium are grown.
| Topic: If Jamie starts with 5 bacteria in the Petri dish draw a graph that displays the total number of bacteria with respect to time from 1200 midnight h 0to 800 a. Setting Up A Bacterial Culture Lab Educational Innovations Blog The Number Of Bacteria Present In A Petri Dish |
| Content: Summary |
| File Format: Google Sheet |
| File size: 2.6mb |
| Number of Pages: 23+ pages |
| Publication Date: June 2017 |
| Open Setting Up A Bacterial Culture Lab Educational Innovations Blog |

Petri Dish Photos Of Antifungal Activity Assay Of Garlic Oil With Download Scientific Diagram 31If you have an image which doesnt work but you think should leave a comment there.
| Topic: There will be bacteria present after one hour. Petri Dish Photos Of Antifungal Activity Assay Of Garlic Oil With Download Scientific Diagram The Number Of Bacteria Present In A Petri Dish |
| Content: Synopsis |
| File Format: PDF |
| File size: 3.4mb |
| Number of Pages: 4+ pages |
| Publication Date: February 2019 |
| Open Petri Dish Photos Of Antifungal Activity Assay Of Garlic Oil With Download Scientific Diagram |

Bacterial Nomenclature 101 And How To Describe A New Species Ezbiocloud Help Center The conditions are such that the number of bacteria is able to double every 25 hours.
| Topic: 26Colonies of bacteria Bacteria are micro-organisms and individual cells cannot be seen without a microscope. Bacterial Nomenclature 101 And How To Describe A New Species Ezbiocloud Help Center The Number Of Bacteria Present In A Petri Dish |
| Content: Summary |
| File Format: Google Sheet |
| File size: 3.4mb |
| Number of Pages: 24+ pages |
| Publication Date: March 2019 |
| Open Bacterial Nomenclature 101 And How To Describe A New Species Ezbiocloud Help Center |

Petri Dish Analysis Reactiv Ip
| Topic: Petri Dish Analysis Reactiv Ip The Number Of Bacteria Present In A Petri Dish |
| Content: Explanation |
| File Format: Google Sheet |
| File size: 6mb |
| Number of Pages: 13+ pages |
| Publication Date: January 2017 |
| Open Petri Dish Analysis Reactiv Ip |

Appearance Of Bacteria Swarming On Agar In A Petri Dish The Scale Bar Download Scientific Diagram
| Topic: Appearance Of Bacteria Swarming On Agar In A Petri Dish The Scale Bar Download Scientific Diagram The Number Of Bacteria Present In A Petri Dish |
| Content: Analysis |
| File Format: PDF |
| File size: 2.3mb |
| Number of Pages: 10+ pages |
| Publication Date: August 2018 |
| Open Appearance Of Bacteria Swarming On Agar In A Petri Dish The Scale Bar Download Scientific Diagram |
The Big Story The Petri Dish The Biomedical Scientist Magazine Of The Ibms
| Topic: The Big Story The Petri Dish The Biomedical Scientist Magazine Of The Ibms The Number Of Bacteria Present In A Petri Dish |
| Content: Answer |
| File Format: PDF |
| File size: 3.4mb |
| Number of Pages: 26+ pages |
| Publication Date: April 2021 |
| Open The Big Story The Petri Dish The Biomedical Scientist Magazine Of The Ibms |

Petri Plates Showing Colonies Of A Heterotrophic Bacteria And B Download Scientific Diagram
| Topic: Petri Plates Showing Colonies Of A Heterotrophic Bacteria And B Download Scientific Diagram The Number Of Bacteria Present In A Petri Dish |
| Content: Learning Guide |
| File Format: DOC |
| File size: 1.8mb |
| Number of Pages: 20+ pages |
| Publication Date: December 2020 |
| Open Petri Plates Showing Colonies Of A Heterotrophic Bacteria And B Download Scientific Diagram |

Culturing Microanisms How To Culture Bacteria Medium Petri Dish Fair Testing Antibiotics Antiseptics To Inhibit Bacterial Growth Antibiotic Resistant Bacteria Inhibition Zones Analysis Of Results Agar Gel Igcse O Level Gcse 9 1 Biology Revision Notes
| Topic: Culturing Microanisms How To Culture Bacteria Medium Petri Dish Fair Testing Antibiotics Antiseptics To Inhibit Bacterial Growth Antibiotic Resistant Bacteria Inhibition Zones Analysis Of Results Agar Gel Igcse O Level Gcse 9 1 Biology Revision Notes The Number Of Bacteria Present In A Petri Dish |
| Content: Analysis |
| File Format: DOC |
| File size: 6mb |
| Number of Pages: 11+ pages |
| Publication Date: July 2021 |
| Open Culturing Microanisms How To Culture Bacteria Medium Petri Dish Fair Testing Antibiotics Antiseptics To Inhibit Bacterial Growth Antibiotic Resistant Bacteria Inhibition Zones Analysis Of Results Agar Gel Igcse O Level Gcse 9 1 Biology Revision Notes |

Culturing Microanisms How To Culture Bacteria Medium Petri Dish Fair Testing Antibiotics Antiseptics To Inhibit Bacterial Growth Antibiotic Resistant Bacteria Inhibition Zones Analysis Of Results Agar Gel Igcse O Level Gcse 9 1 Biology Revision Notes
| Topic: Culturing Microanisms How To Culture Bacteria Medium Petri Dish Fair Testing Antibiotics Antiseptics To Inhibit Bacterial Growth Antibiotic Resistant Bacteria Inhibition Zones Analysis Of Results Agar Gel Igcse O Level Gcse 9 1 Biology Revision Notes The Number Of Bacteria Present In A Petri Dish |
| Content: Solution |
| File Format: PDF |
| File size: 800kb |
| Number of Pages: 20+ pages |
| Publication Date: September 2018 |
| Open Culturing Microanisms How To Culture Bacteria Medium Petri Dish Fair Testing Antibiotics Antiseptics To Inhibit Bacterial Growth Antibiotic Resistant Bacteria Inhibition Zones Analysis Of Results Agar Gel Igcse O Level Gcse 9 1 Biology Revision Notes |
Its really simple to get ready for the number of bacteria present in a petri dish Growing bacteria in petri dishes experiment science experiment bacterial nomenclature 101 and how to describe a new species ezbiocloud help center bacteria petri dish nutrition review what may prevent a unique bacterial colony in a petri dish to spread on the whole surface what would limit the colony area quora petri dish photos of antifungal activity assay of garlic oil with download scientific diagram culturing microanisms how to culture bacteria medium petri dish fair testing antibiotics antiseptics to inhibit bacterial growth antibiotic resistant bacteria inhibition zones analysis of results agar gel igcse o level gcse 9 1 biology revision notes culturing microanisms how to culture bacteria medium petri dish fair testing antibiotics antiseptics to inhibit bacterial growth antibiotic resistant bacteria inhibition zones analysis of results agar gel igcse o level gcse 9 1 biology revision notes office bacteria project what s lurking on your desk the viking blog
No comments:
Post a Comment